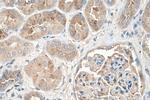
AGT Antibody in Immunohistochemistry (Paraffin) (IHC (P))

Search
Proteintech
AGT Monoclonal Antibody (1B2F5)
{{$productOrderCtrl.translations['antibody.pdp.commerceCard.promotion.promotions']}}
{{$productOrderCtrl.translations['antibody.pdp.commerceCard.promotion.viewpromo']}}
{{$productOrderCtrl.translations['antibody.pdp.commerceCard.promotion.promocode']}}: {{promo.promoCode}} {{promo.promoTitle}} {{promo.promoDescription}}. {{$productOrderCtrl.translations['antibody.pdp.commerceCard.promotion.learnmore']}}
产品信息
68020-1-IG150UL
种属反应
宿主/亚型
分类
类型
克隆号
偶联物
形式
浓度
规格
纯化类型
保存液
内含物
保存条件
运输条件
靶标信息
The protein encoded by AGT, pre-angiotensinogen or angiotensinogen precursor, is expressed in the liver and is cleaved by the enzyme renin in response to lowered blood pressure. The resulting product, angiotensin I, is then cleaved by angiotensin converting enzyme (ACE) to generate the physiologically active enzyme angiotensin II. The protein is involved in maintaining blood pressure and in the pathogenesis of essential hypertension and preeclampsia. Mutations in this gene are associated with susceptibility to essential hypertension, and can cause renal tubular dysgenesis, a severe disorder of renal tubular development. Defects in this gene have also been associated with non-familial structural atrial fibrillation, and inflammatory bowel disease.
仅用于科研。不用于诊断过程。未经明确授权不得转售。
篇参考文献 (0)
生物信息学
蛋白别名: alpha-1 antiproteinase, antitrypsin; angiotensin I; angiotensin II; Angiotensinogen; fetal-liver predominant transporter 1; pre-angiotensinogen; preangiotensinogen; serine (or cysteine) proteinase inhibitor; Serpin A8; serpin peptidase inhibitor, clade A, member 8; unnamed protein product
基因别名: AGT; ANHU; hFLT1; SERPINA8
UniProt ID: (Human) P01019
Entrez Gene ID: (Human) 183, (Pig) 100157073